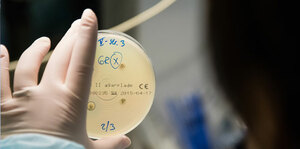
COVID-19 and Practical Considerstions for Antibiotic Stewardship

What I will learn?
By the end of this session, participants will be able to:
- Explain the purpose and scope of the BCPS certification.
- Identify the major content areas and competency domains covered in the BCPS exam.
- Describe the structure, format, and types of questions included in the exam.
- Recognize common challenges in preparing for the BCPS and strategies to overcome them.
- Outline a structured and personalized study plan based on the course design and individual learning needs.